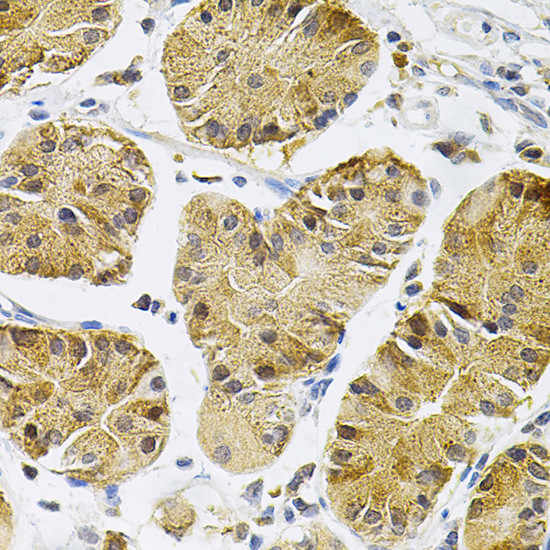
TrkA Antibody in Immunohistochemistry (Paraffin) (IHC (P))

Search
Invitrogen
TrkA Polyclonal Antibody
{{$productOrderCtrl.translations['antibody.pdp.commerceCard.promotion.promotions']}}
{{$productOrderCtrl.translations['antibody.pdp.commerceCard.promotion.viewpromo']}}
{{$productOrderCtrl.translations['antibody.pdp.commerceCard.promotion.promocode']}}: {{promo.promoCode}} {{promo.promoTitle}} {{promo.promoDescription}}. {{$productOrderCtrl.translations['antibody.pdp.commerceCard.promotion.learnmore']}}
图: 1 / 4
TrkA Antibody (PA5-90581) in IHC (P)




Please note: We are reviewing Western blot images included in the antibody testing data in our catalog, including those provided by third parties. Unless expressly labeled or annotated as “raw-unedited”, Western blot images included in the antibody testing data in our catalog may have been edited, optimized or otherwise adjusted for presentation.
产品信息
PA5-90581
种属反应
宿主/亚型
分类
类型
抗原
偶联物
形式
浓度
规格
纯化类型
保存液
内含物
保存条件
运输条件
RRID
产品详细信息
Positive Samples: Mouse brain, Rat brain; Cellular Location: Cell membrane, Early endosome membrane, Late endosome membrane, Single-pass type I membrane protein
Immunogen sequence: LYRKFTTESD VWSFGVVLWE IFTYGKQPWY QLSNTEAIDC ITQGRELERP RACPPEVYAI MRGCWQREPQ QRHSIKDVHA RLQALAQAPP VYLDVLG
靶标信息
NTRK1 (TRKA) belongs to the neurotrophic factor family of related polypeptides central to the development and maintenance of the mammalian nervous system. TrkA is a membrane-bound receptor that, upon neurotrophin binding, phosphorylates itself and members of the MAPK pathway. The presence of TrkA leads to cell differentiation and may play a role in specifying sensory neuron subtypes. Mutations in TrkA have been associated with congenital insensitivity to pain, anhidrosis, self-mutilating behavior, mental retardation and cancer.
仅用于科研。不用于诊断过程。未经明确授权不得转售。
篇参考文献 (0)
生物信息学
蛋白别名: DKFZp781I14186; EC 2.7.10.1; gp140trk; High affinity nerve growth factor receptor; kinase TrkA; Neurotrophic tyrosine kinase receptor type 1; neurotrophic tyrosine kinase, receptor, type 1; Oncogene TRK; p140-TrkA; Slow nerve growth factor receptor; trk; trk tyrosine-specific protein kinase; Trk-A; TRK1-transforming tyrosine kinase protein; TrkA neurotrophin receptor; trkA proto-oncogene receptor; tropomyosin receptor kinase A; Tropomyosin-related kinase A; Tyrosine kinase receptor; Tyrosine kinase receptor A; unnamed protein product
基因别名: C80751; MTC; NTRK1; p140-TrkA; Tkr; TRK; Trk-A; TRK1; TRKA
UniProt ID: (Mouse) Q3UFB7, (Rat) P35739
Entrez Gene ID: (Human) 4914, (Mouse) 18211, (Rat) 59109